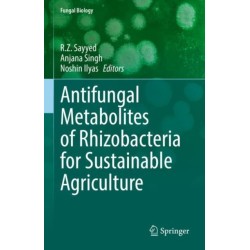
Antifungal Metabolites of Rhizobacteria for Sustainable Agriculture

Ingen varer
Der er 1 underkategori
Videnskabeligt udstyr, forsøg og teknikker
Visning: Type : Alle | Sprog : Alle | Format : Alle
-
Bemærk: Kan ikke leveres før jul.
Critical Points for the Organisation of Test Performance Studies in Microbiology: Plant Pathogens as a Case Study (Bog, Hardback, Engelsk)This open access book in the field of plant pest detection shows a constant demand in development and improvement of fast and reliable detection tools, especially for high-priority pests.
Levering: Skaffevare (forvent 14 - 30 hverdage) -
Bemærk: Kan ikke leveres før jul.
Critical Points for the Organisation of Test Performance Studies in Microbiology: Plant Pathogens as a Case Study (Bog, Paperback / softback, Engelsk)This open access book in the field of plant pest detection shows a constant demand in development and improvement of fast and reliable detection tools, especially for high-priority pests.
Levering: Skaffevare (forvent 14 - 30 hverdage) -
Bemærk: Kan ikke leveres før jul.
Antifungal Metabolites of Rhizobacteria for Sustainable Agriculture (Bog, Hardback, Engelsk)Antifungal Metabolites of Rhizobacteria for Sustainable Agriculture focuses on plant health in agro-ecosystems of various economically important cash and food crops with a concern to promote sustainable agriculture.
Levering: Skaffevare (forvent 14 - 30 hverdage) -
Bemærk: Kan ikke leveres før jul.
Spectrophotometric Determination of Palladium & Platinum: Methods & Reagents (Bog, Hardback, Engelsk)This versatile resource consolidates new and available methods for the determination of palladium and platinum and serves as a... Læs mere
Levering: Skaffevare (forvent 14 - 30 hverdage) -
Bemærk: Kan ikke leveres før jul.
Foundations of Nonlinear Optical Microscopy (Bog, Hardback, Engelsk)Levering: Skaffevare (forvent 14 - 30 hverdage) -
Bemærk: Kan ikke leveres før jul.
Nanoscale Standards by Metrological AFM and Other Instruments (Bog, Hardback, Engelsk)Levering: Skaffevare (forvent 14 - 30 hverdage) -
Bemærk: Kan ikke leveres før jul.
Scanning Force Microscopy: With Applications to Electric, Magnetic and Atomic Forces (Bog, Hardback, Engelsk)This revised edition has been updated to include important new research in scanning force microscopy since the publication of the original edition in 1991. The bibliography has been thoroughly revised. Basic theory, instrumentation and applications are discussed.
Levering: Print on Demand (forvent 14 - 30 hverdage) -
Bemærk: Kan ikke leveres før jul.
Intelligent Data Analysis in Science (Bog, Hardback, Engelsk)This is a fundamental reference work for any scientist contemplating using AI for data analysis.
Levering: Skaffevare (forvent 14 - 30 hverdage) -
Bemærk: Kan ikke leveres før jul.
Sonochemistry (Bog, Paperback / softback, Engelsk)There is an increasing interest in the exploitation of power ultrasound in chemistry and processing (sonochemistry). This text was writtem as a result of the many requests from potential... Læs mere
Levering: Print on Demand (forvent 14 - 30 hverdage) -
Bemærk: Kan ikke leveres før jul.
Computers in Chemistry (Bog, Paperback / softback, Engelsk)Provides an overview of computers and their use in chemistry. This work presents the basic ideas required to understand and exploit computers as encountered by chemistry students... Læs mere
Levering: 6 - 9 hverdage -
Bemærk: Kan ikke leveres før jul.
Principles of Nuclear Magnetic Resonance Microscopy (Bog, Paperback / softback, Engelsk)This highly successful book, details the underlying principles behind the use of magnetic field gradients to image molecular distribution and... Læs mere
Levering: Print on Demand (forvent 14 - 30 hverdage) -
Bemærk: Kan ikke leveres før jul.
Electron Diffraction Techniques: Volume 1 (Bog, Hardback, Engelsk)Part of a two-volume work which explores the theory and applications of electron-diffraction techniques, this book contains introductory chapters and sections on electron diffraction which are less dependent on considerations of imaging in electron microscopes.
Levering: Print on Demand (forvent 14 - 30 hverdage)

 for at udvide
kategorilisten.
for at udvide
kategorilisten.